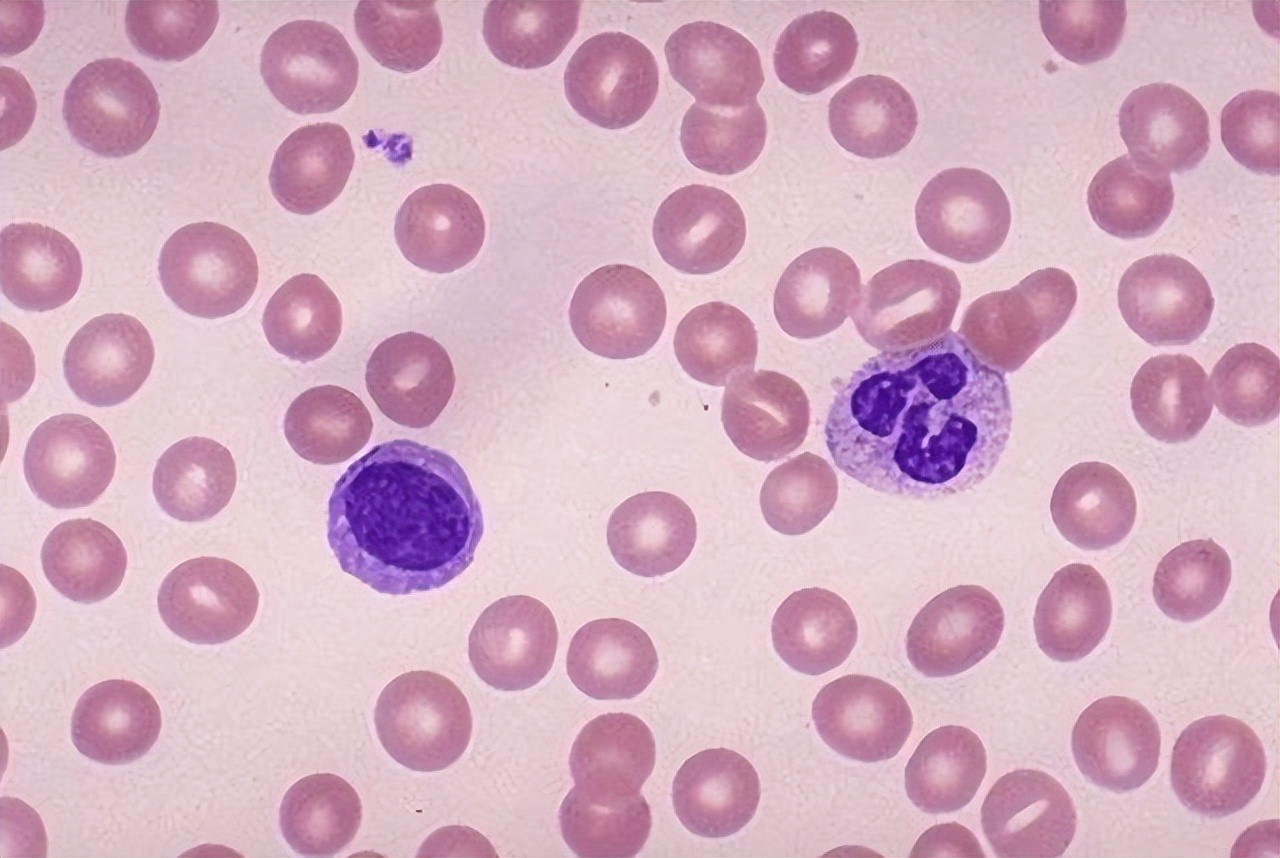
血常规最怕三种指标偏高一点点,血常规检查一些指标偏高一点点

血常规是指通过观察血细胞的数量变化及形态分布从而判断血液状况及疾病的检查,是临床上最基础的化验检查之一,检验的项目包括红细胞、白细胞、血红蛋白及血小板数量等。
如果身体出现异常,那么血常规的指标就会升高,如果血常规的数据属于正常状态,那么也就说明身体是没有问题的,可以帮助医生快速查出病因做出判断。
今天我们就一起来了解一下,血常规检查中,若这5个指标升高,建议再做进一步检查。

血常规检查能查出哪些疾病?
1.贫血
一些女性朋友容易在生理期或者因为其他生理原因而有头晕,气短的症状出现。而这些症状出现的主要原因还是有贫血造成的。如果不确定,可以去做一次血常规检查自身是否有贫血的情况。
因为在进行血常规检查时,可以明显地看到自己体内的血红蛋白高低和红细胞数量的,血红蛋白高低和红细胞数量可以来反映自身是否贫血,血红蛋白过低,则代表着身体已经出现了贫血。

2.血液疾病
血常规是筛查血液疾病的重要手段,当红细胞增多明显时,可见于红细胞增多症。当血小板数量超标时,则是血小板增多症的信号,若血小板减少,通常与再障、白血病、肝脏疾病等情况有关,当然也并不是所有的血小板减少都是白血病信号。
因为白血病在临床上分为多个种类,如果血常规明显异常,比如白细胞数量过低或过高、血小板过低或过高等,都可能是白血病发出的信号。
3.内分泌疾病
通过血常规检查能看一看甲状腺激素水平有没有异常,辅助诊断甲状腺功能减退或亢进;同时也能用来辅助诊断糖尿病,抽血检查能了解空腹、餐后血糖和糖化血红蛋白的情况。

4.感染性的疾病
血常规的检查,对于判断是否有感染,是否有细菌感染,有着非常重要的作用。因为白细胞、中性粒细胞、单核细胞等的高低,对于感染的提示非常重要。有时候还作为判断病毒还是细菌感染的标准之一。
血常规检查中,若这5个指标升高,建议再做进一步检查
1.血红蛋白指数升高
健康人体血红蛋白起到了帮助运输血氧,输送的营养物质,将身体多余的脂质类细胞、低密度脂蛋白、甘油三酯胆固醇比其他毒素垃圾排出体外的作用。
同时在短期内维护人体中枢,神经,心脏及神经功能系统供给血氧,针对缺血性贫血代谢性循环紊乱,起到预防作用。
若是血常规,体检报告显示出患者血红蛋白成分偏高,一定要注意同时进行下一步检查。

2.血小板数量和质量出现异常
血小板是从骨髓中成熟巨核细胞的细胞质中释放出来的小片细胞质,它们的功能是凝血,当人体出血时,血小板将起凝血作用。
血小板数量和质量异常可导致出血性疾病,血小板数量减少主要见于血小板减少性紫癜、再生障碍性贫血和白血病,在原发性血小板增多症、真性红细胞增多症和其他疾病中可以看到数量的增加,当血小板升高时,需要进一步检查。

3.淋巴细胞数量增多
我们的血液中还有淋巴细胞,这件事大家都知道的,如果淋巴细胞数量异常,那么就要考虑是病理性的还是生理性的。
我们在做血常规检查的时候,如果报告上显示淋巴细胞数量增多,那么大家一定要引起重视,可能身体中已经患有炎症,而且比较严重,有可能是癌变或者白血病,建议再做进一步检查。

4.中性粒细胞数增多
在做血常规检查的时候,我们会发现有一个项目叫中性粒细胞,这在血常规检查当中是一个占比较大的细胞,医生会通过观察中性粒细胞的数量来判断是否存在疾病。
一般来说导致中性粒细胞数量发生改变的原因,有生理性和病理性两种,生理性的变化可能是运动量过大或者是在检查之前温度较低所引起的。病理性的要引起高度警惕了,说明身体内有炎症,需要进行治疗。

5.嗜碱粒细胞异常
血常规检查当中通常也会包括白细胞检查,嗜碱粒细胞是白细胞的一种,白细胞是很多细胞的总称,不仅是嗜碱粒细胞,还包括中性粒细胞等。
一般来说,嗜碱粒细胞的含量很少,体内发现嗜碱粒细胞明显增加的情况下,体内患癌症的情况很多,这时要引起重视,进一步做检查。
哪些人需要定期查血常规?建议这几类人必须要查
1.亚健康人群
亚健康是一个时间较长的潜伏状态,平时不容易引起人们的关注,进入中老年后,很多疾病就开始显现出来。
如果不及早进行预防,心脑血管疾病、“三高”等疾病就会找上门。亚健康人群应该进行定期的血液等身体检查,对疾病进行预防和预警,早日脱离亚健康状态是当务之急。
2.慢性疾病人群
慢性病人是指一些已患有糖尿病、心脑血管疾病、肝炎、哮喘、胃病等疾病的人,他们可能在医生的治疗下能暂时得到缓解,但并不代表能够彻底治愈。因此,这些病人仍然应定时进行疾病的复诊和检查。

3.孕妇、产妇
在怀孕过程中,要做的检查有很多,血常规检查是孕产妇不可少的检查。我们通过观察白细胞、红细胞和血小板来判别孕妈是否健康。
在整个孕期中,白细胞指数一旦升高,就说明孕妈的抵抗力正在迅速下降,有感染的可能,如果是轻微的感染,一定要多休息、多喝水。
血常规检查可以查出癌症吗?
普通的血常规检查是无法确诊癌症的,即便做了肿瘤标志物检查也不一定能够确切发现癌症的存在,大家不要把发现癌症寄托在血常规检查上面,如果想要确定自己身体是否有癌症的存在,需要做癌症筛查。
不同的癌症所做的筛查也是不同的,还希望大家能够咨询专业的医生,结合医生的建议进行相关检查。

通过检查出的异常指标大家可以发现身体上所存在的问题,可以进行进一步的检查,这个时候就可以帮助确诊是否有癌症的出现。